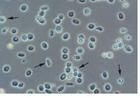
尿沉渣鏡檢

標準
尿沉渣鏡檢尿液沉渣鏡檢篩查標準由於尿液分析儀檢測尿液化學分析影響因素比較多,為了提高檢驗質量,更好的為臨床提供更準確的檢驗報告,要對異常的尿液標本進行離心沉渣顯微鏡檢測。針對本實驗室尿液分析儀分析水平,制定異常尿液標本的鏡檢標準。白細胞、潛血、蛋白質、上皮細胞、亞硝酸鹽中任何一項或多項出現陽性(包括弱陽性)時,均進行顯微鏡檢測尿沉渣。非染色尿沉渣鏡檢操作1、取刻度離心管,倒入混合後的新鮮尿液10ml1500r/min離心5min10ml,15min。2、待離心停止後,取出離心管,棄去上層清液,留下0.2ml沉渣,輕搖離心管,使尿沉渣有形成分充分混勻。3、取尿沉渣0.02ml,滴在載玻片上,用18mm′18mm的蓋玻片復蓋。0.02ml18mm′結果判斷尿沉渣鏡檢觀察,用10′10鏡頭,觀察其中有形成分的全貌及管型。用10′4010′10′鏡頭觀察鑑定細胞成分和計數,應觀察10個視野所見最低和最高值,記錄結果。管型用高倍鏡鑑定,但計數按低倍鏡觀察20個視野,算出一個視野的平均值,記錄結果。參考值1、細胞成分:每高倍鏡視野所見的最低值至最高值:紅細胞0-3/HP3/HP,白細胞0-5/HP5/HP。2、管形(透明):每低倍鏡視野平均值0-1/全片3、尿結晶和鹽類數量以每一高倍視野+,2+,3+,4+報告+2+,3+,4+
臨床套用
尿沉渣鏡檢紅細胞:每高倍視野見到3個以上的紅細胞為異常現象。紅細胞可提示腎臟和系統性的多種疾病,包括腎外傷,也可見於劇烈運動後。紅細胞可見於外傷性的導尿後、結石的通過、或月經的污染。血尿可見於腎孟腎炎、腎結石、腎腫瘤和泌尿道的其他惡變、也可見於出血性疾病.
白細胞:腎移植病人的尿沉渣中見到大量的單個核細胞可提示早期組織排斥現象。
上皮細胞:大量的腎上皮細胞可提示活動性的腎小管變性。這些細胞常見於急性壞死和腎乳頭炎壞死期病人尿沉渣中。鱗狀上皮細胞常見於正常尿液中。
細菌:正常尿液中無細菌存在。標本中大量細菌的存在提示泌尿道感染。標本中白細胞的存在有助於對污染與感染的區分。
酵母菌:酵母菌細胞(白色念珠菌)可提示尿道念珠菌感染,特別是見於糖尿病患者。真菌還常見於女性陰道念珠菌感染者的被污染的尿液中。
寄生蟲:尿中大多數寄生蟲來自糞便或陰道分泌物的污染。尿道寄生蟲感染可與細胞的存在有關,如血吸蟲。
精蟲:精蟲常見於射精和性交後尿液中。
管型:管型常見於腎小球遠曲小管中形成,也可在下行Henle環或集合管中形成。管型形成的條件包括酸性環境、高鹽濃度、尿流量的減少和蛋白的存在。管型是根據其內容物而命名,(如紅細胞管型、白細胞管型等)紅細胞管型提示急性腎小球腎炎、腎梗塞、膠原組織疾病、或亞急性細菌性心內膜炎所致的腎損害的唯一指證。白細胞管型可見於急性腎小球腎炎、腎綜合症或腎盂腎炎的患者尿液中。
由於腎盂腎炎可保持完全無症狀,儘管它可發展到損害腎組織,因此仔細檢查尿沉渣中的白細胞管型是十分重要的。在某些病例中,它是無症狀情況下的唯一的實驗室取證。
上皮細胞管型是由融化的脫層管細胞所形成。因此,偶爾見到一個或成堆的腎性上皮細胞並非異常。但是,在任何引起腎小管損害的疾病中,大量上皮細胞管型的出現可提示上皮的過度脫層,如見於腎疾病、子癇、澱粉樣病變和重金屬中毒或其它毒素的中毒。透明管型形成Tam-Horsfall蛋白的凝膠體,與腎小球毛細管的損害有關,此損害使蛋白質通過腎
小球濾過而漏出。這種損害可以是永久性的也可是暫時性的,是由高熱、體位的影響(軀位、立位)、情緒壓抑或劇烈運動所致。
顆粒管型—“粗顆粒”和“細顆粒”是用於形容管型內容物—細胞破碎顆粒的粗細程度的。在正常尿液中可見到一個顆粒管型。大多數情況下,顆粒管型提示腎盂腎炎。顆粒管型還見於慢性腎臟疾病。
尿沉渣中特殊成分的鑑別
紅細胞:在高倍視野下,紅細胞呈蒼白色、雙凹盤樣。在未經染色的新鮮尿沉渣中,紅細胞呈蒼白色。在非新鮮尿液中,紅細胞呈無色“陰影細胞”。在濃縮尿液中紅細胞可皺縮和變小。在稀釋尿液中紅細胞則通常較大和膨脹,有時破裂形成“鬼”細胞。紅細胞必須與真菌、尿酸鹽結晶和油滴區分開。真菌通常呈卵圓形並有芽孢。尿酸銨結晶有時較大量出現,且較大。礦物油滴的大小變化較大,呈橢圓形且反光。
尿沉渣鏡檢白細胞:尿中白細胞多為分葉形白細胞,這些白細胞有分葉核、顆粒,大小約為紅細胞的1.5倍。某些中性粒細胞比一般的白細胞大,其胞漿顆粒呈Brownian運動。這種白細胞稱作顆粒運動或“GLITTER”細胞。這些細胞最被認為是病理性腎盂腎炎的指征,但現在則被認為是尿液低滲的原因所致。有白細胞存在的尿液對白細胞酯酶試驗應呈陽性反應。
上皮細胞:腎小管上皮細胞呈圓形,比白細胞稍大。每個細胞含有一個較大的核。膀胱上皮細胞比腎小管上皮細胞大,形狀為平板形、矩形或柱形。
鱗狀上皮細胞呈平板形細胞,含單個小核及大量胞漿。這些細胞大多數是由陰道或外陰的污染所致,但有些是來源於尿道。
管型:管型的形狀、大小及內容物將提供尿通道前一個腎臟最少一個腎小球狀況的無可量否的證據。
所有的管型均有一個含有或不含有內容物如來自腎小管上皮的脫層鱗狀上皮細胞,白細胞或紅細胞的透明基質。管型根據其內容物而命名。
紅細胞管型的形成分三個階段:(1)游離紅細胞的存在;(2)在蛋白基質內的細胞裂解;(3)同類血液管型形成。
任何改變了腎小球堅硬性的疾病均可改變尿液的成分。腎小球的疾病或損害導致蛋白和紅細胞滲漏。
白細胞管型通常由大量白細胞形成圓柱形而組成,提示來源於腎臟。
粗顆粒管型包含了同類型的粗顆粒物質。它們呈清晰、無色和緻密樣。粗顆粒管型可代表上皮細胞管型退化的初期。這些管型進一步退化形成細顆粒管型,最終變成臘樣管型或脂肪管型。細顆粒管型與粗顆粒管型的區別是它含有幼細顆粒物質。
臘樣管型由同類的黃色物質組成。它們相對較寬、有一高度反光的輪廓,並顯得很脆。它們呈不規則形狀,有特殊的裂口,偶爾可呈“瓶塞鑽”樣。
寬管型(腎衰管型)較普通管型寬2-6倍。它們常為臘樣、顆粒或細胞型。它們被認為在腎集合中出現是由於嚴重的腎病導致尿排出量的顯著減少所致。
上皮細胞管型由腎小管退化上皮細胞的積聚而形成。獨立的細胞管型分解成粗或細顆粒物質是一純粹的老化功能並使腎小球有疾病的存在這一推論得以認可。
透明管型呈蒼白、無色、偶爾反光的“圓柱狀”。當顯微鏡光線極度減弱時最易觀察到。它們由被推測是來自腎小球毛細管膜的蛋白質凝膠所形成。
結晶:各式各樣的結晶可在尿液中出現。它們可由其特殊的形狀和溶解特性得以識別。
大多數結晶是非病理性的。然而一些結晶則提示病理性情況的存在。胱氨酸結晶提示胱氨酸尿液的存在。這是一種新生兒代謝性疾病,患者有胱氨酸結石在腎臟形成,尿液中、網狀內皮系統、脾臟和眼睛均可發現胱氨酸結晶。
尿酸結晶可以多種形狀和顏色出現於尿中。它們可因病理或代謝的結果而出現。尿酸結晶可呈針狀、六角型、玫瑰狀、“磨刀石”狀或菱形板狀。尿酸結晶可以是無色、黃色或棕色。它的增加是嘌呤代謝增強的結果。尿酸結晶還可見於高燒、白血病、一些腎小管疾病和痛風。
亮氨酸結晶和酪酸結晶屬異常結晶偶爾見於肝病患者的尿液中。當肝疾患嚴重時這些胺基酸則不能代謝。酪氨酸結晶呈無色細針狀,常成堆組合在一起。
細菌:細菌可見於泌尿道感染患者的尿沉渣中或污染的尿標本沉渣中。雖然大量的白細胞的存在、陽性亞硝酸鹽試驗、或陽性白細胞酯酶試驗是泌尿道感染的提示,但感染所致和污染所致的細菌的存在卻不易區分。桿菌較球菌易辨認,後者可被誤認為是無定形結晶。當有懷疑時,應作中斷尿培養。
酵母菌細胞可見於尿沉渣中。它們有時易與紅細胞混淆。與紅細胞的區別在它們呈卵形(非圓形),無色、大小不等。它們還通常有芽孢。大量酵母菌帶菌絲提示陰道炎的存在。
寄生蟲:陰道滴蟲是尿液中最常見的寄生蟲。它是一種帶前鞭毛和波浪形膜的,但與之區別在於其以鞭毛在沉渣中泳動以及其波浪形的膜。
精蟲:精蟲有一帶細長尾巴的卵形軀體。它們可以是運動的,也可是固定不動的。
污染物和偽物:棉花絲、頭髮、澱粉顆粒、木頭、羊毛纖維和其它污染物必須被識別開以確定其在尿沉渣中不具有任何臨床意義。
看懂化驗單
| 每次醫院看病,基本都離不開化驗單。你又是如何來看化驗單的呢? |